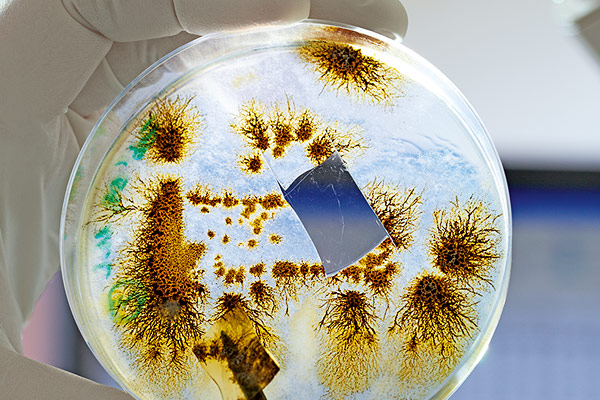

Las plantas no sólo son las protagonistas de la industria agrícola, sino también son la base del medio ambiente de nuestro planeta, y por esto, es importante que comprendamos los factores que determinan la salud o enfermedad de una planta, para implementar estrategias innovadoras que protejan tanto la ecología como los cultivos de todos los agricultores.
Las enfermedades y daños causados por microorganismos patogénicos (hongos, bacterias, virus, etc.) en los campos agrícolas causan pérdidas millonarias cada año a lo largo del mundo. Las medidas que se toman comúnmente para intentar mitigar el daño son implementar control químico y también sembrar variedades de hortalizas que cuenten con resistencias a las enfermedades desde su genética. Pero además de estas soluciones, existe una innovadora solución que puede ser usada como una alternativa a los pesticidas o fertilizantes químicos: el uso de agentes de control biológico.

Antes de abordar este método de manejo, primero tenemos que recordar que el suelo agrícola se divide en tres estructuras: física, química y biológica; esta última incluye microorganismos benéficos que son vitales para tareas diversas, como contribuir en la nutrición del suelo, mejorar el crecimiento de las hortalizas, brindar tolerancia a estrés ambiental y enfermedades, y absorber de mejor manera químicos como nitrógeno, fósforo, potasio y hierro. Por ejemplo, algunas bacterias que conviven en simbiosis con las legumbres se encargan de restaurar los suelos pobres en nitrógeno y de mantener la fertilidad de la tierra.
Entonces, ¿qué es el control biológico? Se trata de la implementación de estos valiosos microorganismos directamente en las plantas o en la tierra, con el fin de obtener algunos de los beneficios de manejo que hemos mencionado, especialmente el control de plagas o enfermedades y la mejora en la calidad de la planta y sus frutos.
Debido a la complejidad que existe en la relación entre cada planta y sus microorganismos, llamados en conjunto microbioma, las investigaciones científicas sobre esta innovación progresan lentamente. Aún así, los expertos en la industria agrícola, en nuestro país instituciones como el Instituto de Biotecnología de la Universidad Autónoma de México y de manera internacional empresas como Bayer con su división Crop Science, se encuentran perfeccionando esta tecnología, obteniendo en el proceso resultados exitosos.
El ejemplo más importante de los agentes de control biológico, debido el éxito que ha tenido en los campos agrícolas, es la aplicación del hongo de género Trichoderma. Los excelentes resultados en los sembradíos de las cepas de Trichoderma se debe a su alta capacidad reproductiva, habilidad para sobrevivir bajo condiciones ambientales desfavorables, eficiencia en la utilización de nutrientes, fuerte agresividad contra hongos fitopatógenos y eficiencia en promoción del crecimiento en los cultivos.

Algunas especies de este hongo pueden ser muy valiosas para los agricultores mexicanos, sobre todo Trichoderma harzianum, que se utiliza en cultivos de tomate, pepino, melón y maíz. La gran ventaja de este microorganismo es que ha demostrado ser efectivo contra especies del hongo Fusarium, que afecta especialmente a las variedades de tomate y además tiene la capacidad de potenciar los daños causados por los nemátodos. Con la aplicación de este hongo benéfico se reduce significativamente la aparición del Fusarium en las raíces y en los frutos maduros del tomate.
El Instituto de Biotecnología de la UNAM en colaboración con el Centro de Investigación en Alimentación y Desarrollo ha demostrado que Trichoderma harzianum es capaz de competir con fungicidas químicos para el control tanto de Fusarium como Pythium en los campos de tomate, mientras que permite obtener frutos de mejor calidad. Estas ventajas son muy atractivas para los mercados tanto nacionales como de exportación, así como para los productores que deseen proteger sus campos y obtener buenas cosechas.

Para obtener resultados aún más efectivos, se recomienda combinar el uso de Trichoderma harzianum con variedades de hortalizas que cuenten con resistencias genéticas a los patógenos y enfermedades. En el caso de tomate, por ejemplo, en Seminis te ofrecemos nuestra variedad DRD 8551 que tiene resistencia a Fusarium y a virosis presentes en el suelo. Haz clic en este enlace si deseas saber más sobre este excelente tomate saladette determinado.
En cuanto a la forma en que se implementa, el género Trichoderma puede ser inoculado en el sustrato para semilleros, directamente en la tierra a campo abierto, o también es posible tratar las semillas con este agente de control, siendo un método muy rápido, fácil y económico. Otra forma de usarlo es mediante su aplicación en residuos vegetales, lo que permite disminuir la población de patógenos en el abono verde y en el suelo. Además, aunque poco practicado, es posible aplicarlo en el follaje de las plantas.
Independientemente del agente de control biológico que desees utilizar, en la práctica debes tener en cuenta todos los aspectos que permitan que este microorganismo realice sus funciones y mecanismos biológicos de manera más eficiente, como implementarlo en un ambiente favorable (temperatura, humedad, presencia de oxígeno), las condiciones del suelo (su estructura, contenido de materia orgánica y nutrientes) e incluso detalles como la hora de su aplicación. Para conocer todas estas variables, apóyate con un especialista que te ayude a analizar las características de tus tierras y de tu región agrícola.

Esta solución en el manejo de hortalizas tiene un cierto nivel de complejidad durante su investigación y desarrollo, pues se trata de una tarea multidisciplinaria en la que trabajan conjuntamente ingenieros agrónomos, fitopatólogos y agricultores. A pesar de estas dificultades, los beneficios que pueden brindar estos innovadores métodos de manejo son evidentes, por lo que estaremos pendientes de su progresiva implementación en México y el mundo.
En conclusión, el uso de agentes de control biológico es un método seguro, efectivo y que encaja bien en sistemas modernos de producción de alimentos. Considerando cómo la tendencia en la industria agrícola de cosechar alimentos de gran calidad y amigables con el medio ambiente va cobrando cada día más importancia, estas herramientas biológicas serán la innovadora respuesta a las necesidades de los agricultores para asegurar la seguridad y rendimiento de sus campos. ¡Gracias por leernos una vez más! Espera más información agronómica en próximos blogs Seminis.
Las recomendaciones en este artículo están basadas en información obtenida de las fuentes citadas y deberán ser usadas como una referencia rápida para información acerca de:
https://www.cropscience.bayer.com/en/blogs/corporate-blog/2017/hanna-roevenich-empowering-plants-to-protect-themselves
https://www.research.bayer.com/en/biological-crop-protection.aspx
http://www.ibt.unam.mx/Geg/lineas/Control%20Biologico%20Ciencia.pdf
https://www.cropscience.bayer.com/en/stories/2017/beneficial-bacteria-and-soil-hidden-helpers-below-ground
https://www.intagri.com/articulos/fitosanidad/trichoderma-control-de-hongos-fitopatogenos
Imágenes obtenidas de los siguientes sitios de internet:
https://www.research.bayer.com/en/biological-crop-protection.aspx
El contenido de este artículo no debe ser sustituido por la opinión profesional de un productor, cultivador, agrónomo, especialista en fitopatología, y profesiones similares relacionadas con este cultivo específico.



